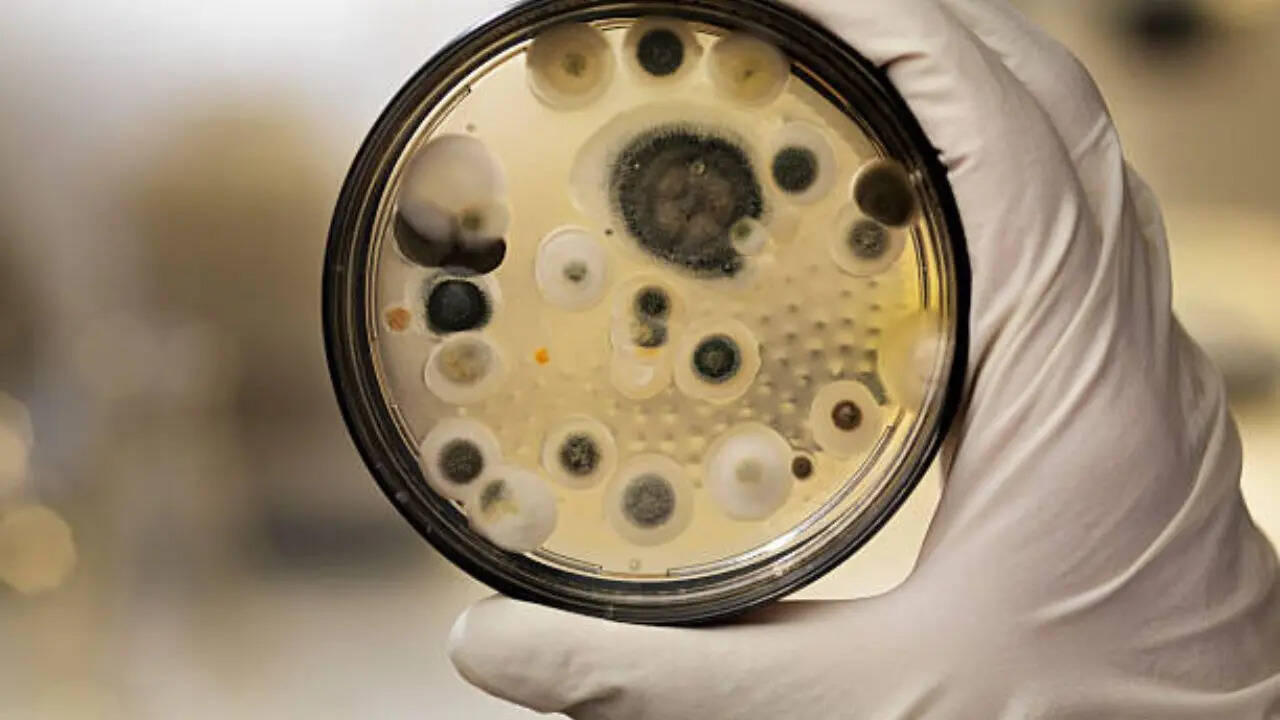
deadly drug-resistant fungus spreading worldwide, new indian study warns

A new Indian study has said the drug-resistant fungal species Candida auris is turning deadlier and spreading globally. Candida auris can lead to serious illness, and some strains are resistant to multiple
drugs. It is hard to treat and spreads in hospitals or long-term care facilities. The study, led by researchers from the Vallabhbhai Patel Chest Institute, University of Delhi, in collaboration with the National Institutes of Health from the United States, has shown that invasive fungal infections are spreading across the globe and gaining in virulence. Researchers say the fungus is affecting more than 6 million people every year. These infections are frequently associated with high mortality rates, often exceeding 50 per cent, even with antifungal therapy. “C. auris has developed wily cellular strategies to survive, including morphogenesis in its ability to switch from yeast growth to filament-driven spread, as well as forming multicellular aggregates, and also switching its phenotypic genetic expression in response to its changing environment,” said the team in the paper published in the journal Microbiology and Molecular Biology Reviews. The fungus is also extremely successful in colonizing human skin, with the molecular evidence showing so far that the proteins of the cell wall attach like a kind of glue to mammalian cells—and even non-living surfaces. Candida auris causes:
- Ear infections
- Wound infections
- Urinary tract infections
- Infections in your blood that spread to the rest of your body
Signs and symptoms of a Candida auris infection?
A few symptoms of a C. auris infection depend on where in your body the fungus infects. Some symptoms could include:- Fever
- Chills
- Lethargy or extreme tiredness
- Low blood pressure
- High heart rate or tachycardia
- Low body temperature or hypothermia
- Pain, pressure, or feeling of fullness in your ear
/images/ppid_a911dc6a-image-176715004788029752.webp)

/images/ppid_a911dc6a-image-177083903258342419.webp)




/images/ppid_59c68470-image-177083752855419301.webp)

/images/ppid_59c68470-image-177083752668871927.webp)


/images/ppid_a911dc6a-image-177083556748629873.webp)
/images/ppid_a911dc6a-image-177083563836656334.webp)